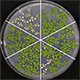

研究成果(プレスリリース)2018

2018年12月28日
植物由来抗がん剤の仕組み
2018年12月20日
結晶の中でタンパク質の“生きた状態”の観察に成功
2018年12月19日
乾燥しても死なない細胞はなぜ死なずに生き返ることができるのか?
2018年12月18日
巨大ブラックホール周辺の磁場を初めて測定
2018年12月17日
エッジデバイス上で高精度な認識処理を実現する深層ニューラルネットワークのコンパクト化技術を開発
2018年12月11日
宇宙初期物質の小さなしずくを創成
2018年12月10日
温度応答性ナノカプセル
2018年12月8日
マルチフェロイクス材料における電流誘起磁化反転を実現
2018年12月7日
光応答性ポリマーを用いた培養細胞の自動高速レーザープロセシング
2018年12月6日
脊椎動物の半規管の進化
2018年12月6日
磁気渦と反渦の正方格子を世界で初めて観察
2018年12月5日
植物病原菌の巧妙な認識回避機構
2018年12月4日
強誘電体から発現するトポロジカルなスピン励起
2018年11月29日
半導体量子ビットによるハイブリッド量子計算手法の実証
2018年11月29日
X線レーザーを10nm以下まで集光できる鏡を開発
2018年11月28日
有機合成反応で乳がん手術を改革
2018年11月28日
皮膚で触覚が生まれる仕組みの一端を解明
2018年11月27日
メチルは端だが役に立つ?
2018年11月26日
正信頼度データからの機械学習
2018年11月22日
シグナル伝達に関わる三量体Gタンパク質が細胞膜を離れて細胞質にとどまる仕組みを原子レベルで解明
2018年11月22日
目の丸い形ができる仕組みを解明
2018年11月21日
原子の無秩序な動きに駆動される絶縁体-金属相転移
2018年11月20日
神経細胞を明るくカラフルに染めることで神経回路研究を加速
2018年11月20日
肥満における慢性炎症の新規発症メカニズムの解明
2018年11月17日
磁気渦の新しい生成機構を発見
2018年11月16日
母乳が赤ちゃんの腸内細菌叢を制御する機構の解明
2018年11月14日
意思決定の脳内機構と個体差
2018年11月13日
運動失調症にカルシウム動態の異常が関連
2018年11月12日
固体/液体界面の電気二重層を真空中で精密解析
2018年11月8日
ナノ多孔性材料を室温で高核偏極化することに世界で初めて成功

2018年11月6日
乾燥に適応するためのホルモン制御
2018年11月5日
「期待感」は痛みを和らげる
2018年11月5日
肥満によるインスリン抵抗性の新しい分子機構を解明
2018年11月2日
高温超電導線材の超電導接合を持つ永久電流NMR
2018年11月1日
電子の液体状態と固体状態の競合を観測
2018年10月30日
運動する細胞の進行方向を決める仕組みを解明
2018年10月26日
低温X線回折イメージング・トモグラフィー技術の確立
2018年10月25日
中性子によるコンクリート内塩分の非破壊測定

2018年10月24日
アモルファス高分子の高次構造形成や粘度上昇をもたらす分子ユニット
2018年10月19日
中性子過剰なスズ同位体の巨大共鳴観測に成功
2018年10月19日
キノコの新しい生理活性物質
2018年10月19日
クライオ電顕像からのタンパク質構造モデリングを高速化
2018年10月15日
乳がんの「ゲノム医療」に貢献
2018年10月12日
マウスES細胞から機能的な唾液腺器官の再生に成功
2018年10月11日
ポリコム複合体による発生シグナルの閾値調節機構を解明
2018年10月9日
サメのゲノムを解読
2018年10月6日
炎症の回復期に出現し、組織修復を促す新しい免疫細胞を発見
2018年10月6日
超伝導不揮発メモリの実現
2018年10月5日
日本最大の全ゲノム解析で統合失調症の新規リスク遺伝子同定に成功
2018年10月5日
真核生物での遺伝子読み取りの仕組みを解明
2018年10月4日
バイオマス生産性を向上させた環境ストレス耐性植物の開発
2018年10月2日
植物ホルモンのマスター転写因子BIL1/BZR1の特異的な立体構造を解明
2018年10月2日
水銀原子核はハムレット
2018年10月1日
心不全などさまざまな病態を引き起こす微小管結合タンパク質MAP4の構造を高精度に解明
2018年9月27日
太陽電池駆動の皮膚貼付け型心電計測デバイスを開発
2018年9月26日
細胞内1分子自動観察システム「AiSIS」
2018年9月21日
バイオマスから油脂を生産する新種の酵母を発見
2018年9月21日
自己修復する耐熱性の多孔性結晶を開拓
2018年9月19日
細胞膜の受容体1分子の動きから薬効を評価
2018年9月18日
AIを用いた胎児心臓超音波スクリーニング
2018年9月18日
アンジュレータの放射線耐性が飛躍的に向上
2018年9月18日
植物の病原菌感染を防ぐ画期的な植物免疫強化剤を開発
2018年9月15日
三次元的に乱れた新しいスキルミオン相の発見
2018年9月13日
植物の双葉を2枚にする酵素を発見
2018年9月12日
AIで世界最高精度のNMR化学シフト予測を達成
2018年9月11日
トランスオミクス解析による高濃度と低濃度のインスリン作用の選択性の解明
2018年9月5日
新たなT細胞分化制御機構を発見
2018年9月4日
超新星爆発ニュートリノで宇宙核時計テクネチウム98が生成されることを予言
2018年9月3日
生まれたばかりの原始星に惑星系のもとになる円盤構造を発見
2018年8月31日
高速回転で探る磁石中の電子の回転運動の消失
2018年8月31日
電子ビームの時間幅「1,000兆分の1秒」の評価法を開発
2018年8月31日
人工知能でタンパク質を自動設計
2018年8月29日
植物の水の通り道を自在に制御する
2018年8月29日
レム睡眠に必須な遺伝子を発見

2018年8月27日
データポータビリティと安全性を満たすeポートフォリオの運用法を考案
2018年8月24日
AIによる有機分子の設計とその実験的検証に成功
2018年8月22日
X線の2光子吸収分光法を実現
2018年8月22日
引っ張ったグラフェンの運命を「京」により予想
2018年8月22日
水溶性化合物による組織透明化の化学
2018年8月20日
貧血予防に新たな指針
2018年8月13日
原子核形状の2次相転移をスパコンシミュレーションで発見
2018年8月11日
スキルミオン弦の電流駆動
2018年8月8日
「がんエピゲノム」を検出する新手法
2018年8月8日
スチレン類の二官能基化型ペルフルオロアルキル化反応
2018年8月7日
アシュワガンダ薬用成分の生合成遺伝子を発見
2018年8月6日
タンパク質メチル化阻害剤を評価する新手法
2018年8月6日
アルツハイマー病の原因遺伝子を新しく同定
2018年8月3日
電子構造のトポロジーに由来した巨大なホール効果を発見
2018年8月3日
銅酸化物高温超伝導体で2次元の強磁性ゆらぎを世界で初めて観測
2018年8月3日
プラズマ誕生の瞬間を観測
2018年8月3日
動物間コミュニケーションの新戦略を発見
2018年7月31日
細胞中のタンパク質を全部光らせる
2018年7月31日
SACLAにより銅キューブ粒子の内部構造変化を可視化
2018年7月31日
量子効果で10倍以上の磁気熱電効果を室温で実現
2018年7月30日
疾患モデルマウス作製の効率化に成功
2018年7月30日
タンパク質の結晶化を実験的に診断
2018年7月27日
海馬記憶エングラムからの記憶解読
2018年7月26日
超微量糖鎖分析法を開発
2018年7月26日
管腔臓器の長さと太さが決まる仕組みを解明
2018年7月26日
銀河中心「巨大ガンマ線バブル」の謎に迫る
2018年7月26日
横浜ゴム、バイオマスからイソプレンを生成する世界初の新技術を開発
2018年7月24日
IgAは腸内細菌間の相互作用を誘導する
2018年7月24日
磁気渦の生成・消滅過程を100分の1秒単位で観測
2018年7月21日
AIで早期胃がん領域の高精度検出に成功
2018年7月21日
磁性半導体の磁気単極子による電子の伝導制御
2018年7月20日
天の川銀河を包むプラズマの起源を解明
2018年7月20日
多様な植物に侵入するペプチドの探索
2018年7月20日
クローン胚の新たなエピゲノム異常を発見
2018年7月17日
非染色・非侵襲・短時間で細菌を判別する光技術
2018年7月13日
植物の一挙一動を監視する
2018年7月12日
カルシウム超重同位体研究へ大きな一歩
2018年7月10日
磁化プラトー相の量子スピンダイナミクスの解明
2018年7月10日
希少原子核の高効率・高分解能質量測定による新しい魔法数34の確証
2018年7月6日
植物の高温耐性に寄与するリパーゼ遺伝子を発見
2018年7月6日
組織を走る波による器官の形作りの調節
2018年7月5日
鏡像異性体を作り分ける酵素の発見
2018年7月4日
がんを糖鎖のパターンで識別
2018年6月28日
マウス内で金属触媒によるカップリング反応
2018年6月27日
恐怖記憶を抑制するドーパミン信号
2018年6月27日
植物工場栽培のサニーレタスは旨み成分を多く含み、苦み成分が少ない
2018年6月26日
正しい運動を実行するための運動学習の仕組みの解明
2018年6月21日
炎症性腸疾患発症に関わる複雑な遺伝子発現制御機構
2018年6月19日
光による植物遺伝子の新たな発現制御機構を解明
2018年6月19日
数理モデルによる細胞分裂期の染色体ダイナミクスを解析
2018年6月16日
SiCパワー半導体技術を用いた高出力高安定化電源の開発
2018年6月15日
ゴーストサイトメトリー
2018年6月15日
フェムト秒スケールのタンパク質分子動画
2018年6月14日
タンパク質の共凝集化による精神障害の発現
2018年6月13日
ゲノム中のウイルスを抑制する仕組みの解明
2018年6月12日
多人種解析により心房細動の新しい遺伝子マーカーを同定
2018年6月11日
双極性障害におけるミトコンドリアとセロトニンの関係
2018年6月6日
1細胞RNA分画解読法の開発に成功
2018年6月5日
知的障害における記憶再生の異常
2018年5月31日
電子伝導性配位構造体を用いたエネルギー貯蔵機構の発見
2018年5月31日
中性子の寿命の仕組みを垣間見る
2018年5月30日
隣り合わないスピン量子ビット間の量子もつれ生成に成功
2018年5月29日
雷雲に隠れた天然の加速器を雷が破壊する瞬間を捉えた
2018年5月29日
クモ糸が形成される初期機構を解明
2018年5月29日
活性型ビタミンB12がラジカル酵素反応を制御する仕組みを世界で初めて発見
2018年5月29日
スキルミオン結晶の崩壊と再結晶化を直接観察
2018年5月28日
日本人におけるレアバリアントの心筋梗塞発症への関与を解明
2018年5月26日
「電子液晶」が超伝導に与える影響を直接観測
2018年5月25日
オカラミンの化学構造と殺虫活性の関係
2018年5月24日
上下の環境が異なる特定元素のみをマッピングする基礎技術を実証
2018年5月24日
新粒子「ダイオメガ」
2018年5月23日
B型肝炎ウイルスのゲノム組み込みとがん化の関連を解明
2018年5月22日
トポロジカル母物質のキャリア制御に成功
2018年5月22日
生物の形質改良を加速する新しいゲノム改良技術の発明
2018年5月22日
レタスは光強度・光質により代謝を自在に改変する
2018年5月21日
超好熱菌由来タンパク質の熱安定化機構の解明
2018年5月17日
塩耐性を強化する植物ペプチドの発見
2018年5月16日
赤外超短パルスレーザーの新しい増幅法を実証
2018年5月15日
1分子計測のデータ同化による生体分子構造ダイナミクス
2018年5月15日
遺伝情報に学ぶ化学触媒設計
2018年5月14日
バルク結晶と薄膜結晶で異なるスピン状態を直接観測
2018年5月11日
卵子の染色体を守る新たな仕組み
2018年5月10日
微小タンパク質結晶から迅速に構造決定
2018年5月10日
腫瘍の増大に関わる糖鎖を発見
2018年5月8日
結核感染による宿主遺伝子発現の網羅的解析
2018年5月8日
内在性レトロウイルスを抑え込む普遍的な仕組み
2018年5月7日
深部微細構造を鮮明かつ定量的にイメージングする自動球面収差補正システムを共同開発
2018年5月4日
ゲノム編集でアルツハイマー病を予防する
2018年5月4日
ナノの光で起こる化学反応
2018年5月2日
海洋微生物生態が織り成す「環境予測科学」を始動
2018年5月1日
超高感度3次元マイクロ流体SERSセンサーを開発
2018年4月27日
生体分子を構成する原子のイオンの散乱因子の決定
2018年4月26日
有機太陽電池の界面構造を解明
2018年4月24日
全ゲノムシークエンス解析で日本人の適応進化を解明
2018年4月24日
非環式レチノイドによるMYCN陽性肝がん幹細胞の排除
2018年4月23日
糖鎖L4が炎症を抑える仕組みを解明
2018年4月19日
SACLAにおける光渦照射による針状構造の形成
2018年4月18日
ウイルス感染防御に必須の抗体が作られる経路を発見
2018年4月17日
膜タンパク質のダイナミックな構造変化を解明
2018年4月17日
耐熱性・高効率・超薄型有機太陽電池
2018年4月16日
爬虫類ソメワケササクレヤモリの全ゲノム解読
2018年4月14日
あなたの骨を作ります
2018年4月13日
真空の謎に迫る精密実験始動
2018年4月11日
土壌中の酸素濃度を感知して植物に窒素栄養を供給するタンパク質の全体像を解明
2018年4月11日
翻訳中tRNAの網羅的解析手法を開発
2018年4月5日
光合成細菌光捕集タンパク質複合体の正確な三次元原子構造を解明
2018年4月5日
乾燥に強くなる植物ペプチドを発見
2018年4月4日
多様な記憶キラーT細胞が形成される仕組みを解明
2018年4月3日
てんかん治療薬遺伝子型検査の臨床的有用性を実証
2018年3月30日
マウスは ラットの性シグナルを天敵情報として認識して身をすくめる
2018年3月29日
温和な環境で働く人工脱窒触媒
2018年3月29日
メンデレビウム同位体を始め6個の超ウラン元素同位体の直接質量測定に初めて成功
2018年3月27日
高純度なヒトiPS細胞由来網膜神経節細胞の作製
2018年3月26日
ヒトの脳全体シミュレーションを可能にするアルゴリズム
2018年3月22日
アミロイド構造の多様性の原因解明
2018年3月16日
材料設計におけるAIの有用性を実証
2018年3月15日
翻訳を促進するアンチセンスRNAの機能解析
2018年3月15日
てんかん原因遺伝子ICKの発見
2018年3月14日
新たなリズム時計の発見
2018年3月14日
異質倍数体植物における祖先種由来のストレス応答機構
2018年3月14日
多感覚情報の統合機構
2018年3月13日
数千個の1細胞からRNA量と種類を正確に計測
2018年3月13日
大気中のチリが雲に与える影響を正確に再現
2018年3月13日
脳卒中発症に関わる22の新しい遺伝的変異を同定
2018年3月12日
糖尿病の膵島移植治療に画期的移植法を開発
2018年3月12日
多剤排出トランスポーターの薬剤排出機構を解明
2018年3月8日
1細胞解像度を有する点描脳アトラスの創出
2018年3月8日
極限的な乾燥耐性をつかさどる制御因子を同定
2018年3月2日
ヒトES細胞由来網膜の移植後機能を確認
2018年3月1日
機能分子を「結合できる手」を持つシルクの高効率生産を実現
2018年3月1日
X線ハーモニックセパレーター
2018年2月27日
病原菌における抗菌ガス分解酵素の新機能
2018年2月26日
価数の揺らぎが引き起こす電子の「量子」超臨界状態の発見
2018年2月26日
ペプチドでシルク素材を高強度化
2018年2月23日
理研クリック試薬の誕生
2018年2月23日
脳の深部を非侵襲的に観察できる人工生物発光システムAkaBLI
2018年2月22日
天然魚類と環境水・底泥のエコインフォマティクス
2018年2月22日
植物の光化学系Ⅱ複合体の形成因子を同定
2018年2月22日
光親和性標識法の新たな分子ツール
2018年2月21日
麻疹(はしか)ウイルスに対する感染阻害剤の作用メカニズムを解明
2018年2月21日
虚血性心疾患に保護効果を示す化合物を開発
2018年2月19日
開放隅角緑内障に関わる新たな7遺伝子領域を同定
2018年2月17日
鉄腐食の原因菌が電子を引き抜く酵素を持つことを証明
2018年2月16日
胆道がんの原因遺伝子変異と発生起源細胞を同定
2018年2月15日
髄膜炎菌がタンパク質に糖をつける独特な仕組み
2018年2月15日
植物の再生を司る遺伝子制御ネットワーク
2018年2月14日
RET融合遺伝子上に生じるアロステリック効果を持つ二次変異
2018年2月14日
植物の根毛の成長を止める仕組みの解明
2018年2月14日
1細胞から多種多様なRNAのふるまいを計測
2018年2月13日
物質の内部に隠れたトポロジーの直接観測に成功
2018年2月13日
B細胞を作る最初の分子スイッチを発見
2018年2月9日
睡眠中に脳回路がクールダウンされる仕組みを解明
2018年2月9日
光変換を起こすナノ粒子による新しい光遺伝学法の開発
2018年2月8日
脳型学習で主要な信号を抽出
2018年2月6日
難治性神経変性疾患「アレキサンダー病」の原因分子を発見
2018年2月6日
植物の根の伸長を支えるストレス応答機構
2018年2月6日
58の臨床検査値に影響する遺伝的背景を解明
2018年2月5日
糖鎖構造から衝突断面積を予測
2018年2月5日
軽量化を可能にする鋼材開発に向けた新たな分析手法の確立
2018年1月31日
第0脳神経(終神経)の機能に新たな視点
2018年1月30日
細胞種ごとの遺伝子解析の新手法
2018年1月30日
磁気構造のトポロジーを用いた熱から電気への高効率変換技術
2018年1月29日
磁気光学効果の新たな起源を解明
2018年1月24日
深層学習を用いた重要代謝物探索法
2018年1月24日
免疫組織発生の進化過程を解明
2018年1月22日
天然ゴムノキの研究基盤データベースを構築
2018年1月18日
10分ごとに更新する気象予測
2018年1月17日
緑藻“プロトテカ”が真っ白になった理由
2018年1月17日
新しい二重スリット実験
2018年1月17日
集光XFELパルスの空間コヒーレンスを正しく評価
2018年1月17日
鉛吸着材に使えるコケの新たな生物機能を発見
2018年1月16日
M細胞分化の分子メカニズムを解明
2018年1月15日
酸化物界面におけるスキルミオンの電界制御
2018年1月12日
タイコグラフィ-X線吸収微細構造法の開発
2018年1月12日
他者の空間位置を認識する仕組みを発見
2018年1月10日
毛包イメージングによる毛周期モニタリング
2018年1月10日
水に特有の物理的特性の起源を解明
2018年1月9日
極小世界のビリヤード実験
2018年1月9日
ロイコトリエンB4受容体の構造
